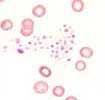

Definition:
In certain patients, the platelets can aggregate in blood anticoagulated with EDTA. In these cases, automatic cell counting devices incorrectly measure low values (pseudo-thrombocytopenia). Good cell counting devices provide indications that the measured value can not be taken at face value. A platelet count taken from capillary blood shows normal values. Aggregation can also be avoided by use of another anticoagulant (e.g. citrate phosphate tris solution). For this reason, the diagnosis of thrombocytopenia found for the first time should always be confirmed visually in a blood film. Platelet aggregate are found microscopically in pseudo-thrombocytopenia.